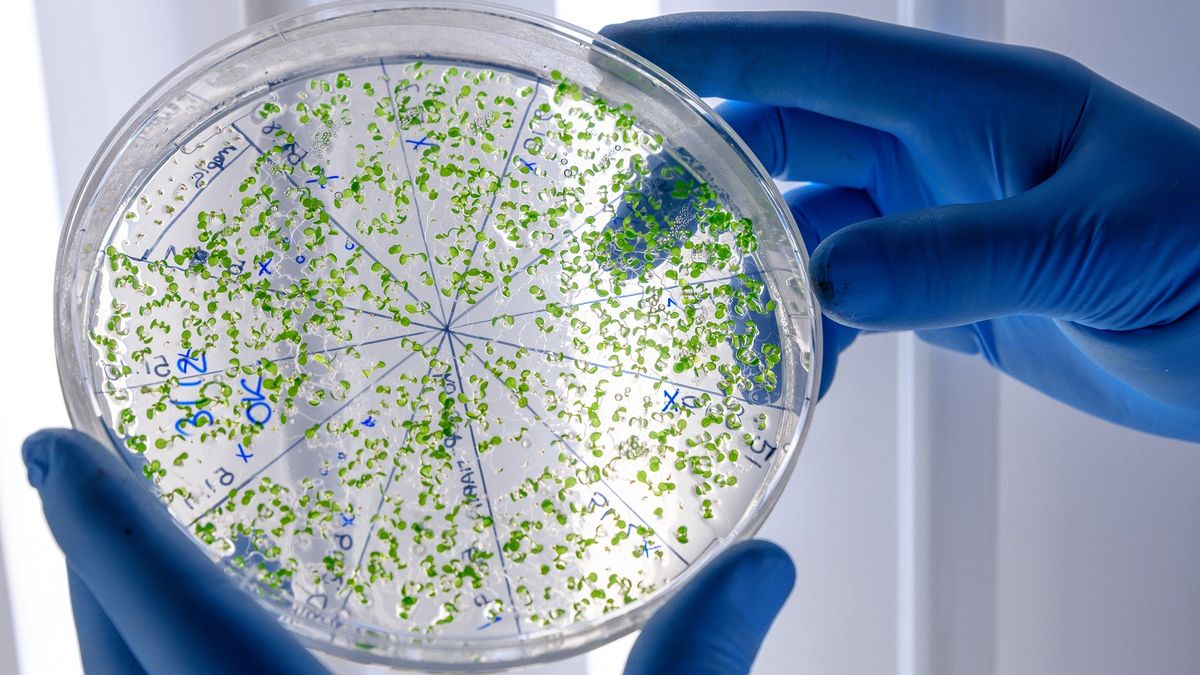
Bacterías: comunidades invisibles que toman decisiones colectivas

LOS ANDES
LOS ANDES
Bacterías: comunidades invisibles que toman decisiones colectivas
Las bacterias rara vez viven aisladas: perciben su entorno, intercambian señales y se organizan en biofilms que transforman su fisiología y su capacidad de adaptación.
Go to News Site